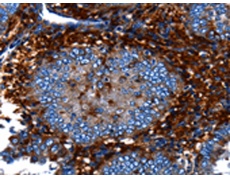
一抗

中文名稱:兔抗CNGA2多克隆抗體
|
Background: |
The protein encoded by this gene represents the alpha subunit of a cyclic nucleotide-gated olfactory channel. The encoded protein contains a carboxy-terminal leucine zipper that mediates channel formation. Odorant signal transduction is probably mediated by a G-protein coupled cascade using cAMP as second messenger. The olfactory channel can be shown to be activated by cyclic nucleotides which leads to a depolarization of olfactory sensory neurons. |
|
Applications: |
ELISA, IHC |
|
Name of antibody: |
CNGA2 |
|
Immunogen: |
Fusion protein of human CNGA2 |
|
Full name: |
cyclic nucleotide gated channel alpha 2 |
|
Synonyms: |
CNCA, CNG2, CNCA1, OCNC1, OCNCa, OCNCALPHA |
|
SwissProt: |
Q16280 |
|
ELISA Recommended dilution: |
1000-5000 |
|
IHC positive control: |
Human cervical cancer and human liver cancer |
|
IHC Recommend dilution: |
50-200 |

 購(gòu)物車
購(gòu)物車 幫助
幫助
 021-54845833/15800441009
021-54845833/15800441009